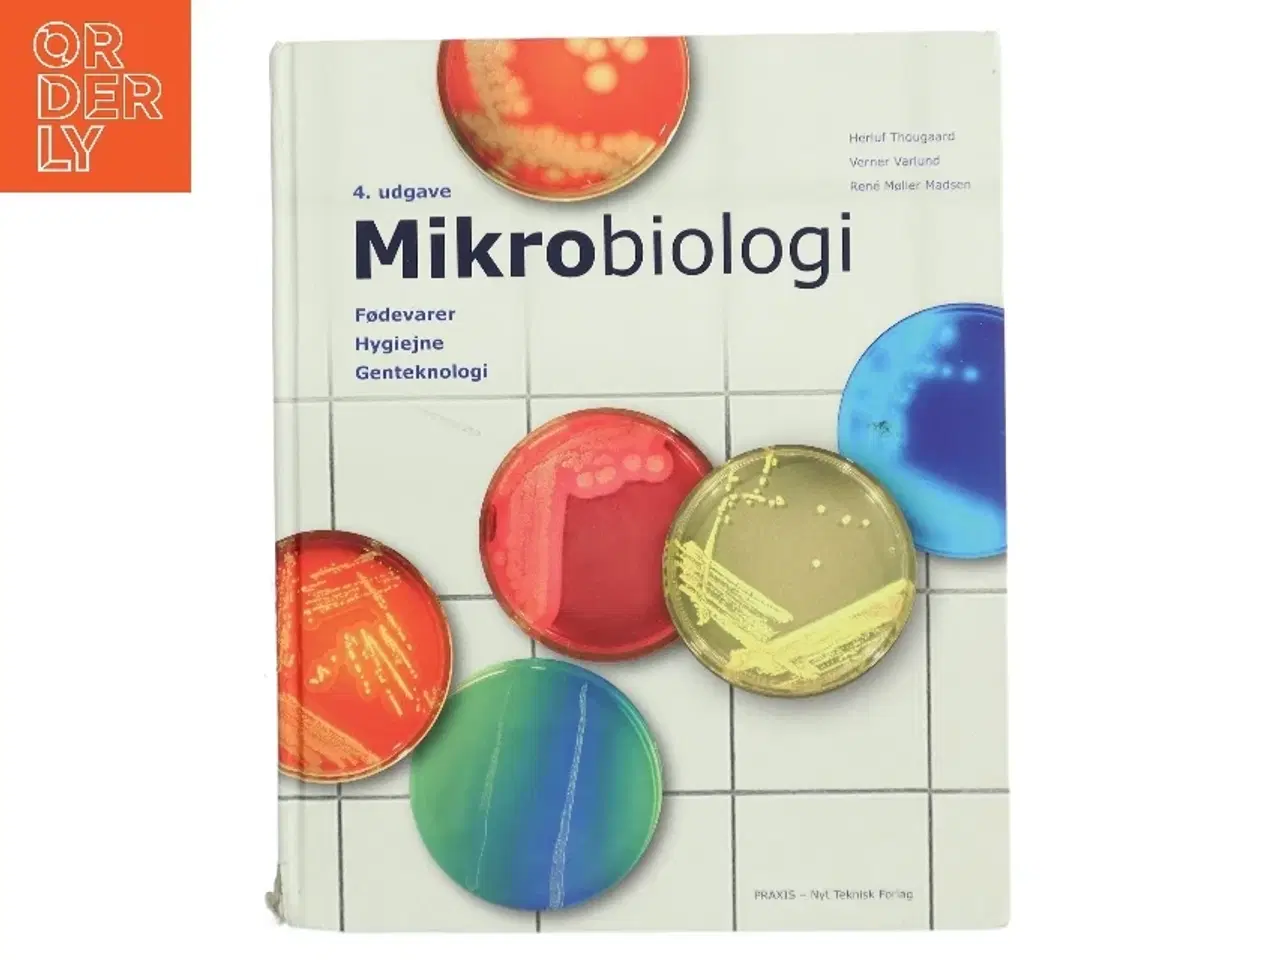
Billede 1 - Mikrobiologi : systematik, vækst, fødevarer af Herluf Thougaard (Bog)

Mikrobiologi : systematik, vækst, fødevarer af Herluf Thougaard (Bog)
60 kr.
Klik på 'Se annoncen hos forhandleren' for at se varen i vores webshop Forfatter: Herluf Thougaard Sprog: Dansk Antal sider: 455 Forlag: Praxis - Nyt Teknisk Forlag Udgivelsesår: 2018 Titel: Mikrobiologi : systematik, vækst, fødevarer Forfattere: Herluf Thougaard,Verner Varlund,René Møller Madsen Udgave: 4. udgave Genre: Faglitteratur Sammendrag: Denne bog gennemgår den grundlæggende mikrobiologi med særlig fokus på de tre fagområder: Fødevarer, hygiejne og genteknologi. Bogen giver en god forståelse af de forskellige celletyper og deres funktion. Desuden beskrives svampe, virus, protozoer, alger og parasitter. Et kapitel behandler mikroorganismer hos mennesker og dyr. Geneteknologiens vigtigste principper beskrives, og der er kapitler om fødevareproduktion, konservering, fermentering og produktionshygiejne. Der afsluttes med praktiske laboratorieøvelser samt ordforklaringer. Type: Hardcover Brugt til laborantstudiet. Alm slid - tekst overstreget med highlighter / noter i bogen kan forekomme (ikke sikkert). Brand: Ukendt Farve: Ukendt Stand: 60 - Mindre spor fra almindeligt brugt. (Se billeder) Vi sender til hele landet for 49 kr. Leveringstiden er 1-3 hverdage. Du kan også gratis hente den på vores lager på Industrivej 10 i Slangerup. Er du i tvivl om varen stadig er til salg? Klik på knappen "Se annoncen hos forhandleren" for at se den i vores webshop. Kan du se den der, er den stadig til salg Orderly er en ny måde at købe brugt på. Vi har alle vores sælgeres ting på vores centrale lager. Derfor kan du være helt sikker på at få dine ting - og du kan samle flere ting på tværs af sælgere og kun betale én gang fragt.
Se annoncen hos forhandleren
Orderly Shop
Send med priser fra 44 kr.
Køb fragt hos Gul&Gratis

Ny
Ny Ny
Ny Ny
Ny Ny
Ny Ny
Ny Ny
Ny Ny
Ny Ny
Ny